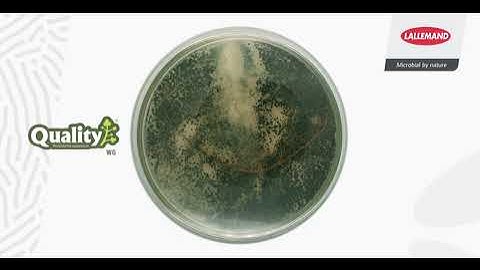
Time-lapse Quality (Trichoderma asperellum)

⬇ DOWNLOAD NOW
Kalau muncul iklan pop-up, tutup lalu klik tombol kembali
Download lagu Evolução de um fungo trichoderma/ time lapse secara gratis hanya untuk keperluan promosi. Dukung artis favorit kamu dengan membeli musik original di iTunes atau platform resmi lainnya.
 This fungi time-lapse, took 12 days to complete
This fungi time-lapse, took 12 days to complete
 Trichoderma Mold Fungi Timelapse
Trichoderma Mold Fungi Timelapse
Time-lapse Quality (Trichoderma asperellum)
Time-lapse Quality (Trichoderma asperellum)
 Fungi Fighting Timelapse
Fungi Fighting Timelapse
 "Fantastic Fungi" time-lapses by Stephen Axford
"Fantastic Fungi" time-lapses by Stephen Axford
 Biocontrol: Fungal inhibition by bacteria - Timelapse
Biocontrol: Fungal inhibition by bacteria - Timelapse
 Woodland fungi growing time lapses. Fly agaric, Shaggy ink and Earthstar
Woodland fungi growing time lapses. Fly agaric, Shaggy ink and Earthstar
 Trichoderma Viride Timelapse
Trichoderma Viride Timelapse